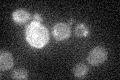
YBR163W
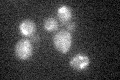
YBR163W

View description
Mitochondrial 5'-3' exonuclease and sliding exonuclease, required for mitochondrial genome maintenance; distantly related to the RecB nuclease domain of bacterial RecBCD recombinases; may be regulated by the transcription factor Ace2
Localization:
Intensity:
Fold change:
Significance:
-
C’ GFP library in SD
mitochondria17.42 -
N' NOP1pr-GFP in SD

mitochondria80.1935 -
N' TEF2pr-mCherry in SD

mitochondria11.66 -
N' NATIVEpr-GFP in SD

cytosol,mitochondria20.7225 -
N' TEF2pr-VC and Cyto-VN in SD

#N/A0 -
C’ GFP library in SD+DTT

mitochondria20.661.18No -
C’ GFP library in SD+H2O2
mitochondria18.391.05No -
C’ GFP library in Starvation Media

mitochondria16.480.94No -
C’ GFP library on the background of Pup2-DaMP

mitochondria -
C’ GFP library on the background of CCT mutant

mitochondria21.27421.22096No
